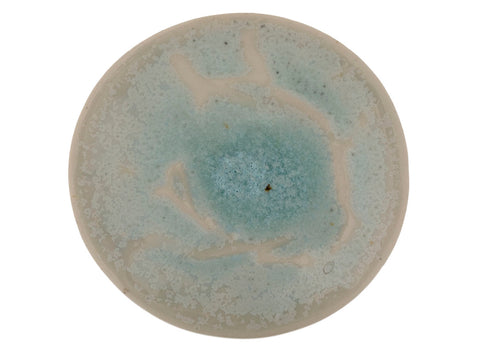
Gaiwan handmade  Moychay # 41766, ceramic/hand painting, 147 ml.

Gaiwan handmade Moychay # 41766, ceramic/hand painting, 147 ml.
No reviews
No reviews
Title
Regular price
€153,12
Fully handmade, firing in an electric furnace of Moychay.com
Diameter: 106 mm.
Height: 67 mm.
Share
Gaiwan handmade Moychay # 41766, ceramic/hand painting, 147 ml.
€153,12


